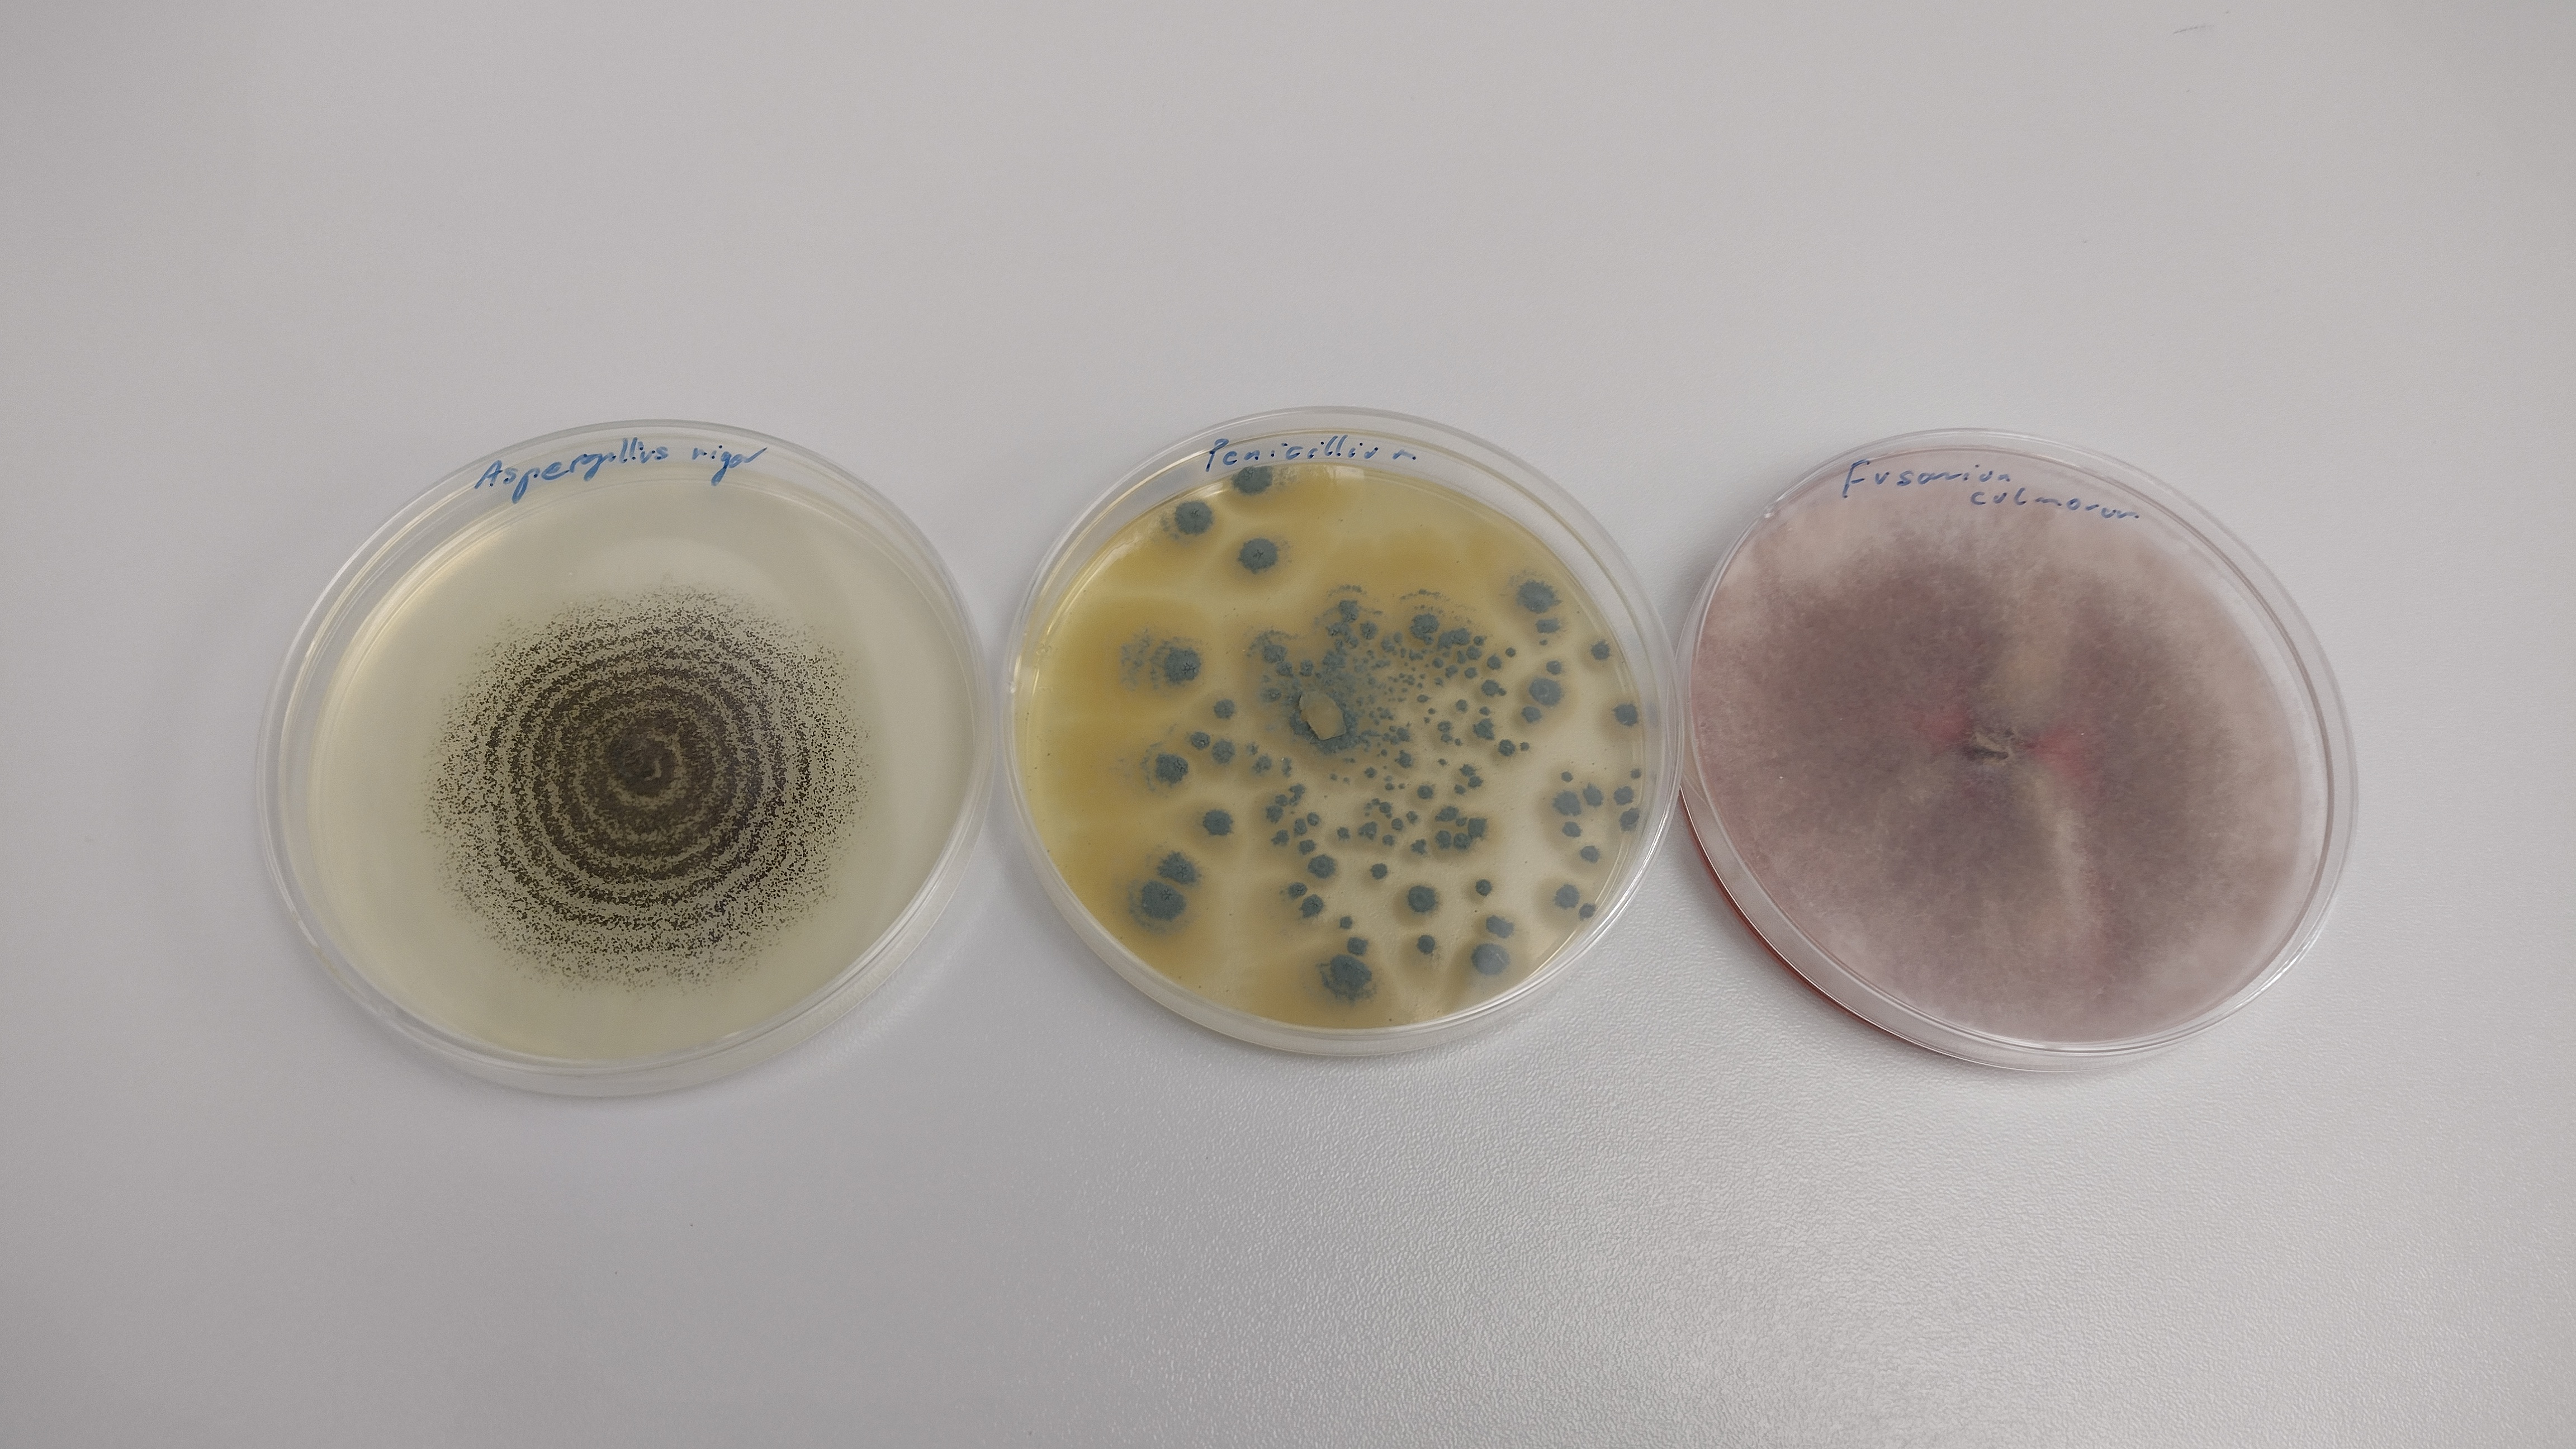

PODNOSZENIE KOMPETENCJI MERYTORYCZNYCH PRACOWNIKÓW WIORiN W POZNANIU
11.03.2026
Od teorii do praktyki laboratoryjnej - relacja ze szkoleń poświęconych chorobom roślin

Stawiamy na wiedzę i profesjonalizm
W lutym 2026 roku przedstawicielka Poznańskiego Oddziału WIORiN w Poznaniu, uczestniczyła w dwóch specjalistycznych kursach zorganizowanych przez Wydział Rolnictwa, Ogrodnictwa i Biotechnologii Uniwersytetu Przyrodniczego w Poznaniu. Kursy odbyły się w ramach projektu „Najlepsi z natury! Podnoszenie kompetencji osób dorosłych przez UPP” i dotyczyły następujących tematów:
- „Choroby roślin sadowniczych w uprawach ekologicznych i integrowanych” – prowadzony przez dr hab. Lidię Irzykowską,
- „Choroby roślin w środowisku miejskim” – prowadzony przez dr hab. Romana Andrzejaka Prof. UPP.
Każdy z kursów trwał 30 godzin i łączył część teoretyczną przeprowadzoną w formie wykładów, z praktyką laboratoryjną. Podczas zajęć uczestniczka zgłębiała wiedzę z zakresu etiologii i symptomatologii chorób występujących w sadach oraz wśród zieleni miejskiej. Ważnym elementem części praktycznej było samodzielne szczepienie na sztucznych pożywkach grzybów z rodzaju Trichoderma. Organizmy te odgrywają kluczową rolę w biologicznej ochronie roślin, skutecznie ograniczając rozwój patogenów takich jak Rhizoctonia solani, Phytophthora, Fusarium, Alternaria alternata, Sclerotinia sclerotiorum, Verticillium dahliae czy Botrytis cinerea, a także patogenów bakteryjnych i wirusowych.
Zdobyta wiedza i umiejętności praktyczne przełożą się bezpośrednio na jakość realizowanych zadań kontrolnych. Dzięki szkoleniu uczestniczka zyskała nowe narzędzia do skutecznej diagnostyki chorób roślin w terenie.
Udział w szkoleniach zakończył się pozytywnym wynikiem testu wiedzy, co zostało potwierdzone stosownymi certyfikatami.
Kursy zostały zrealizowane w ramach projektu „Najlepsi z natury! Podnoszenie kompetencji osób dorosłych przez UPP”, współfinansowanego ze środków Europejskiego Funduszu Społecznego Plus w ramach programu Fundusze Europejskie dla Rozwoju Społecznego 2021–2027.
Autorka tekstu i zdjęć: Greta Żarów-Baran
Wszelkie treści zamieszczone na tej stronie internetowej (teksty, zdjęcia itp.) podlegają ochronie prawnej na podstawie przepisów ustawy z dnia 4 lutego 1994 r. o prawie autorskim i prawach pokrewnych (tekst jednolity Dz. U. z 2025 r. poz. 24). WIORiN wyraża zgodę na wykorzystanie całości lub części powyższej informacji, pod warunkiem podania źródła i odnośnika do adresu strony internetowej http://www.gov.pl/web/wiorin-poznan
Zdjęcia (15)
 Pokaż zdjęcie 2 z galerii.
Pokaż zdjęcie 2 z galerii.
 Pokaż zdjęcie 3 z galerii.
Pokaż zdjęcie 3 z galerii.
 Pokaż zdjęcie 4 z galerii.
Pokaż zdjęcie 4 z galerii.
 Pokaż zdjęcie 5 z galerii.
Pokaż zdjęcie 5 z galerii.
 Pokaż zdjęcie 6 z galerii.
Pokaż zdjęcie 6 z galerii.
 Pokaż zdjęcie 7 z galerii.
Pokaż zdjęcie 7 z galerii.
 Pokaż zdjęcie 8 z galerii.
Pokaż zdjęcie 8 z galerii.
 Pokaż zdjęcie 9 z galerii.
Pokaż zdjęcie 9 z galerii.
 Pokaż zdjęcie 10 z galerii.
Pokaż zdjęcie 10 z galerii.
 Pokaż zdjęcie 11 z galerii.
Pokaż zdjęcie 11 z galerii.
 Pokaż zdjęcie 12 z galerii.
Pokaż zdjęcie 12 z galerii.
 Pokaż zdjęcie 13 z galerii.
Pokaż zdjęcie 13 z galerii.
 Pokaż zdjęcie 14 z galerii.
Pokaż zdjęcie 14 z galerii.
 Pokaż zdjęcie 15 z galerii.
Pokaż zdjęcie 15 z galerii.